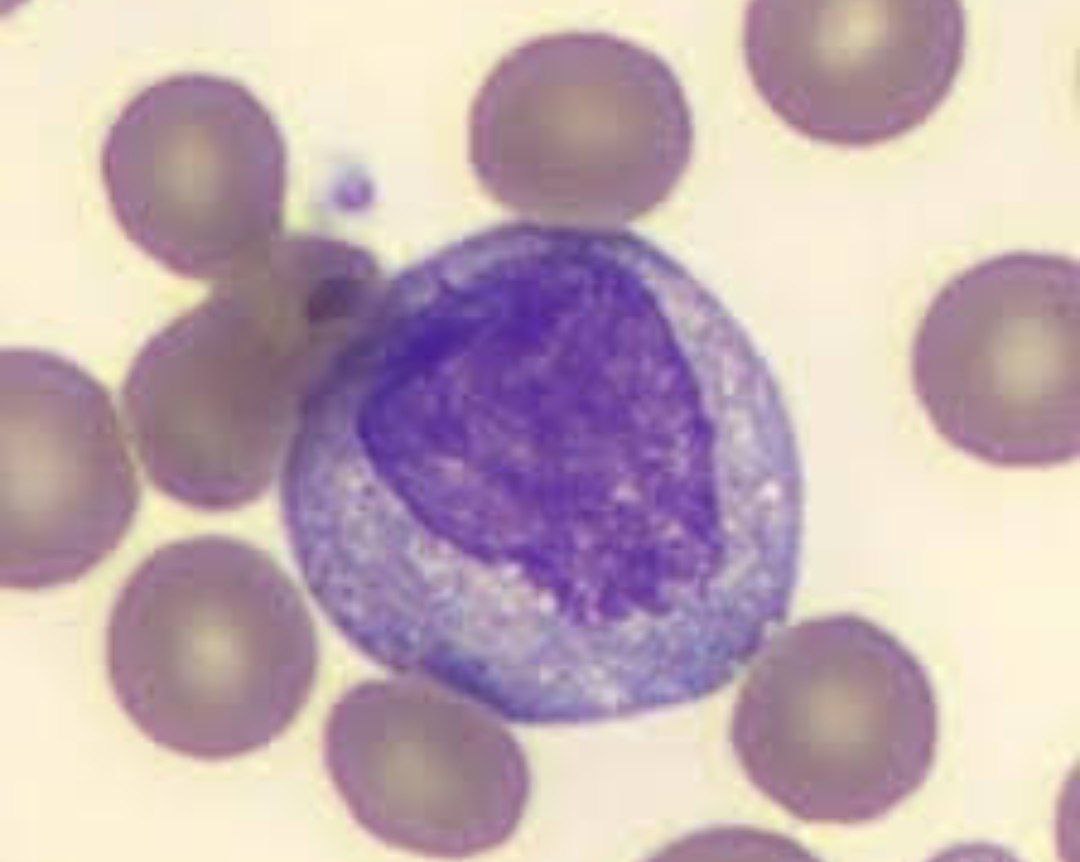
محمد جلالی

پیچ
تاریخ ایجاد: 1404/06/10
توضیحات
استفاده از اسکنر بافتی دیجیتال و هوش مصنوعی پردازش... (برای اطلاعات بیشتر در این رویداد شرکت کنید!)
زمان برگزاری
1404/07/03
15:00
مدت زمان: 5 دقیقه
مکان برگزاری
محل دائمی نمایشگاههای بینالمللی تهران، بزرگراه چمران، خیابان سئول، سالن 8 و 9
شرکتکنندگان
محمد جلالی جلالی
jalali13821382@gmail.com

سارا پوربافرانی
spourbafrani@gmail.com

محسانه رضائیان
rezaiyanmehsaneh@gmail.com

غزل نوروزی اصفهانی
ghazalnoroozi.e@gmail.com